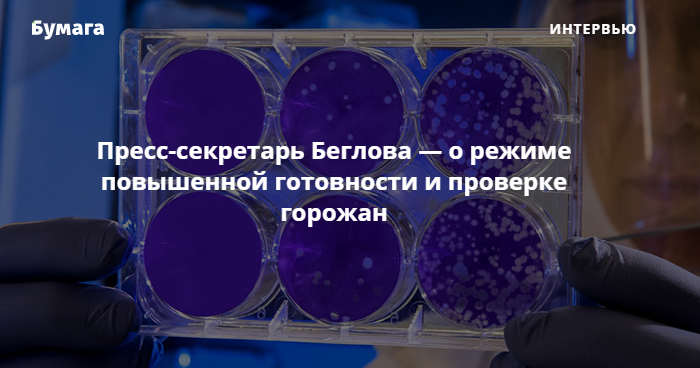

Интервью с пресс-секретарем Беглова о коронавирусе
Губернатор Петербурга Александр Беглов подписал постановление о введении режима повышенной готовности из-за распространения коронавируса. С 16 марта до 30 апреля в городе запретили все массовые мероприятия, где ожидается больше 1 тысячи человек. Правительство рекомендовало создать в каждом районе условия для добровольной проверки на коронавирус. Всех, кто прибыл из неблагополучных по коронавирусу стран, просят самоизолироваться.
«Бумага» поговорила о коронавирусе в Петербурге с пресс-секретарем губернатора Инной Карпушиной.
— Будет ли у Александра Беглова выступление по поводу распространения коронавируса? Если да, то когда и о чем именно? Если нет, то почему?
— Александр Дмитриевич периодически комментирует ситуацию с распространением коронавирусной инфекции, отвечает на вопросы журналистов. Записывает видеообращения для своей страницы во «ВКонтакте», где они доступны в том числе для СМИ. Развернутые комментарии дают специалисты-медики: вице-губернатор Олег Эргашев, председатель комитета по здравоохранению Дмитрий Лисовец и их заместители. В том числе — председатель комитета по социальной политике Александр Ржаненков.
Одной из важнейших задач в периоды пандемий является недопущение панических настроений. Власти города руководствуются этим правилом и предоставляют только актуальную и достоверную информацию, чтобы избежать спекуляций на этой важнейшей теме.
— Что для Петербурга будет значить режим повышенной готовности из-за угрозы распространения коронавируса?
— Сегодня подписано постановление Правительства Санкт-Петербурга о введении на территории Санкт-Петербурга режима повышенной готовности для органов управления и сил Санкт-Петербургской территориальной подсистемы единой государственной системы предупреждения и ликвидации чрезвычайных ситуаций. Оно достаточно объемно и опубликовано на официальном ресурсе Администрации Губернатора Санкт-Петербурга.
В частности, постановлением предусмотрена помощь со стороны структурных подразделений исполнительных органов государственной власти Санкт-Петербурга в адрес [исполнительных органов государственной власти] Ленинградской области в проведении мероприятий по нераспространению коронавирусной инфекции.
— Почему в Петербурге было решено брать под медицинское наблюдение только тех, кто вернулся из признанных неблагоприятными по коронавирусу стран и у кого есть симптомы? Почему нельзя проверять всех?
— Проверяют все прибывающие рейсы. Путешественникам рекомендовано сообщать о своем посещении стран с эпидемически неблагоприятной обстановкой диспетчерам службы 112. Они ведут соответствующие формуляры. При появлении симптомов ОРВИ заболевшим рекомендовано вызывать врача на дом. Их госпитализируют в клиническую инфекционную больницу Боткина, где проводят исследования на наличие коронавируса.
Пациентов с симптомами ОРВИ, которые не были за рубежом, госпитализируют во Введенскую больницу.
— Почему в Петербурге было решено проводить тестирование на коронавирусную инфекцию только после госпитализации в инфекционные боксы? Это чья-то рекомендация?
— Обследование на наличие коронавирусной инфекции происходит при обращении за медицинской помощью.
Вместе с тем, постановлением Правительства Санкт-Петербурга в каждом районе рекомендовано создать условия для забора биологического материала для проведения исследований, чтобы граждане могли добровольно обследоваться на наличие коронавирусной инфекции.
Список адресов будет опубликован на сайте комитета по здравоохранению.